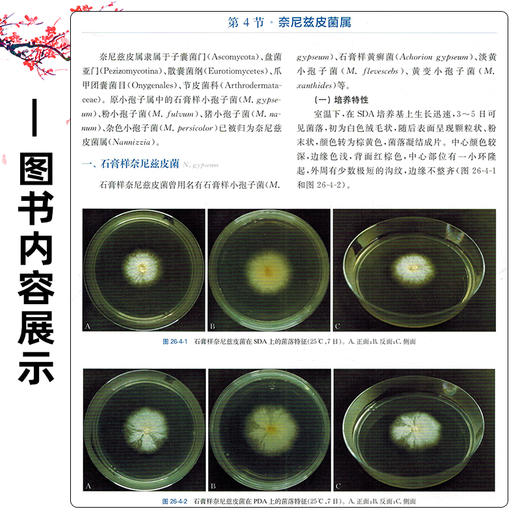
(全2册)临床微生物学诊断与图解（第5五版 上下册）周庭银 主编 临床微生物诊断参考书籍微生物学9787547871850上海科学技术出版社 商品图4

(全2册)临床微生物学诊断与图解(第5五版 上下册)周庭银 主编 临床微生物诊断参考书籍微生物学9787547871850上海科学技术出版社
¥460.60
| 运费: | ¥ 0.00-98.00 |
商品详情
书名:(全2册)临床微生物学诊断与图解(第5版上下册)
定价:658.0
ISBN:9787547871850
版次:5
出版时间:2025-11
内容提要:
定价:658.0
ISBN:9787547871850
版次:5
出版时间:2025-11
内容提要:














- 北京好友图书
- 北京好友医药科技图书中心是一家以经营医药卫生类图书、教材、音像制品为主的图书公司。公司成立二十年来,奉行“老老实实做人、本本分分做事”的诚信经商理念,在医药图书领域和广大医学读者中树立了良好的声誉。
- 扫描二维码,访问我们的微信店铺